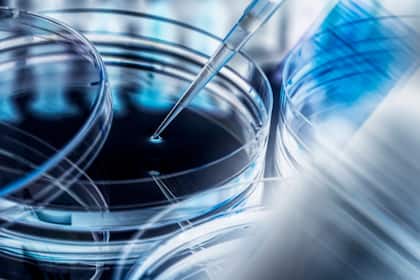
Gehen Pharmaaktien als Gewinner aus dem 2024 hervor? Pipettier-Einheit bei einem Biotechnologie-Unternehmen.

- Home
- Insider Briefing
Insider Briefing
Zum cash Insider Briefing
Unmittelbar vor Börsenstart: Das Briefing vom cash Insider bringt die letzten Marktnews, Gerüchte, Spekulationen und die neuen Aktienempfehlungen. Kurz und prägnant. Börsentäglich um 8:30 Uhr.